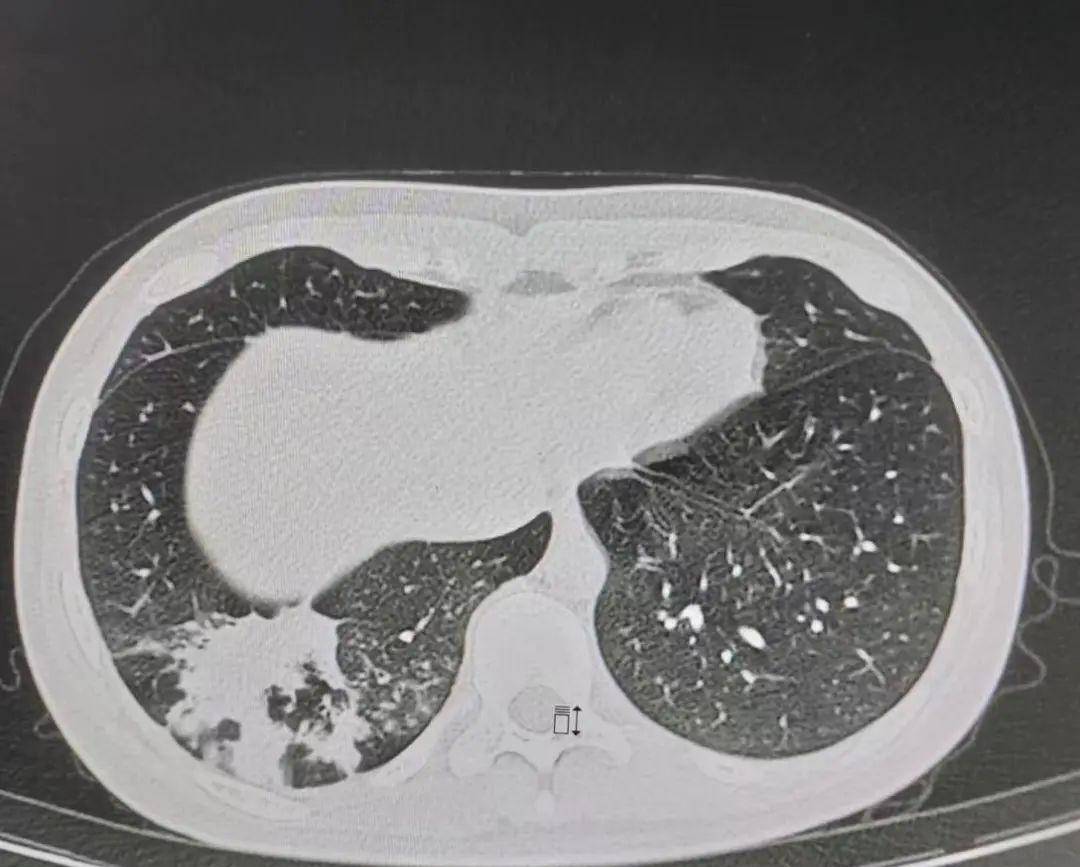
16岁少女确定支原体肺炎,症状迟迟未好转,抗菌药物该如何选择?

支原体感染CT

支原体肺炎该有的 ct 特点,这个患者都有了_临床_病例_检查
图片尺寸1080x747
支原体肺炎之早期影像特点
图片尺寸872x719
16岁少女确定支原体肺炎,症状迟迟未好转,抗菌药物该如何选择?
图片尺寸1080x867
一问告诉你支原体病毒性及细菌性肺炎ct怎么看再说学不会就说不过去了
图片尺寸918x1140
肺炎支原体肺炎的诊断与治疗
图片尺寸855x605
支原体肺炎肺部损害
图片尺寸4096x3072
三例儿童支原体肺炎_临床_支气管_治疗
图片尺寸707x508
你想知道的都在这里|支原体|肺炎|支原体感染_新浪新闻
图片尺寸700x319
儿童肺炎支原体肺炎诊治攻略,这篇值得收藏
图片尺寸1079x887
3例儿童支原体肺炎
图片尺寸679x571
肺炎支原体肺炎时,ct怎么看?
图片尺寸950x663
ct发现右侧肺炎,多发的斑片影,沿支气管周围分布(提示气道吸入性感
图片尺寸512x512
支原体肺炎跟病毒肺炎一样,可以家庭传播,教你用ct鉴别它俩
图片尺寸640x543
支原体感染
图片尺寸2667x2000
支原体肺炎影像学ct
图片尺寸600x406
肺炎支原体肺炎时,ct怎么看?
图片尺寸1080x754
当前位置>首页>新闻动态>医院新闻>正文最近全国各地支原体感染高发
图片尺寸946x685
说说我家姐姐的重症支原体肺炎
图片尺寸1080x1920
山羊支原体肺炎的ct影像分析
图片尺寸700x940
丁香园论坛
图片尺寸3120x4160